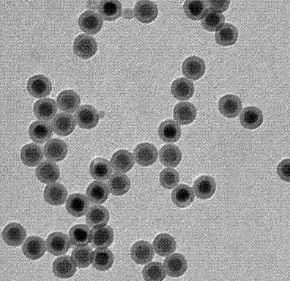
1.png

介孔硅/氨基修饰的介孔硅(50nm)Amino mesoporous silica nanoparticles
发布时间:2023-05-10 作者:ssl 分享到:
氨基修饰的介孔硅 100nm
【产品名称】 氨基介孔二氧化硅纳米颗粒
【英文名称】Amino mesoporous silica nanoparticles
【成分】 氨基介孔二氧化硅纳米颗粒
【用途】 介孔二氧化硅纳米颗粒是一种用途非常的多孔材料,在催化、吸附、分离、传感和生物医学等领域都有着的应用和研究,介孔二氧化硅纳米颗粒的孔径可以将各种分子装入其种包括各种水溶性不好的,另外在到达目的地之前,MSNs能够保护其中的不被过早的释放。通过表面改性技术使介孔二氧化硅纳米颗粒表面带有氨基活性基团,便于进一步在表面偶联相关物质。基科生物提供粒径100-300nm氨基修饰介孔二氧化硅纳米颗粒。
西安齐岳生物科技有限公司供应合成磷脂、PEG磷脂、两亲嵌段共聚物,磁性纳米颗粒,纳米金,荧光量子点及树枝状聚合物、PEG衍生物等等产品.可供常规磷脂单体、PEG磷脂,改性磷脂,磷脂、聚合物磷脂、磷脂偶连无机纳米材料及微球类材料、单分散小分子PEG磷脂偶连产品,还可根据客户需要定制合成复杂及特殊的聚合物磷脂产品。
厂家:西安齐岳生物科技有限公司
用途:科研
状态:固体/粉末/溶液
产地:西安
保存:冷藏
温馨提醒:仅供科研,不能用于人体实验
相关产品:
树枝状介孔硅(50-60nm)
普通介孔硅(40-50nm)
普通介孔硅(50-70nm)
氨基化介孔硅(50nm)
Cu-TCPP(Fe)纳米片(100-200nm)
季铵盐单宁酸壳聚糖ROS响应水凝胶
普通二氧化硅(40-79nm)
中空二氧化(80-100nm)
OX-BCD(100nm-200nm)
磁性四氧化三铁(100nm)




 齐岳微信公众号
齐岳微信公众号 官方微信
官方微信 库存查询
库存查询